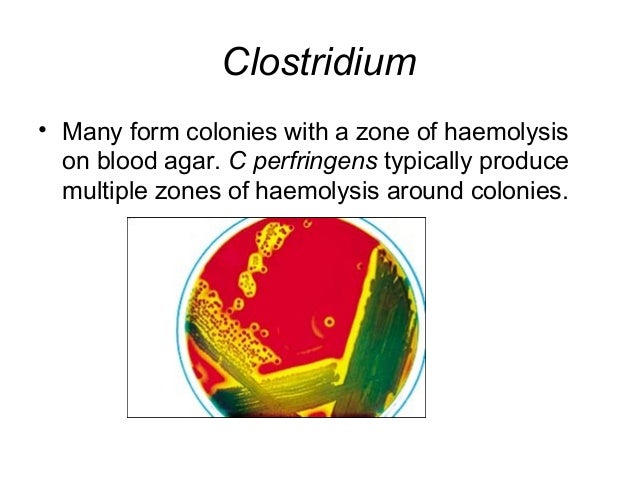

More than 2,600 of 4,500 species are estimated to be uncultured and have never been isolated in the laboratory 3, 4, despite including members that are believed to play an important biological role that remains undiscovered 2, 5. The number of bacterial cells residing in the body of human is estimated to be approximately 40-trillion bacterial cells 2, consisting of several hundreds of bacterial species out of total 4,500 estimated for all human on the earth 3.

The crosstalks of host-gut microbes interaction plays a crucial role in the health and disease of human being 1. This approach would advance the research on spore-forming Clostridia that contains important but difficult-to-cultured bacteria associate with host health and diseases. These results demonstrate that the culturable range of bacteria in intestine can be widened using the germination-inducing activity of BAs. Eventually, we isolated 72 bacterial species of which 61 are known and 11 novel. There were several types of bacteria associated with different sensitivity to each BA. These colonized bacteria mostly belonged to class Clostridia, mainly consisting of families Lachnospiraceae, Clostridiaceae, and Peptostreptococcaceae.
It was found that conjugated-BAs, notably three glycine-conjugated BAs, glycodeoxycholic acid and glycochenodeoxycholic acid, significantly increased the number and the species variety of colonies formed on the agar plate. To test a hypothesis that other BAs also promote germination of intestinal bacteria, we attempted culture of bacteria from ethanol-treated feces by using a series of BAs. Taurocholic acid, a conjugated form of BA, has been reported to be a factor triggering germination of a wide range of spore-forming bacteria in intestine. Structurally-diversified bile acids (BAs) are involved in shaping of intestinal microbiota as well as absorption of dietary lipids.
